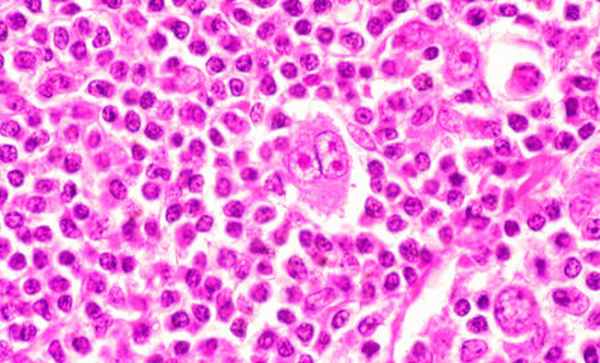
Причины развития неходжкинских лимфом
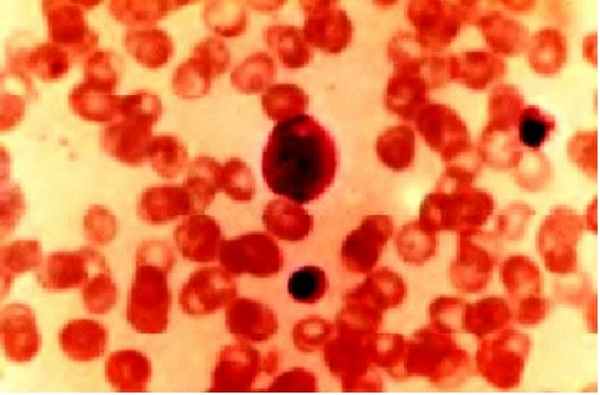
NL007

Установление стадии неходжкинских лимфом
Добавил пользователь Skiper Обновлено: 13.12.2025
Неходжкинские лимфомы (НХЛ) — это группа системных злокачественных опухолей из клеток лимфоидной ткани, возникающих вне костного мозга. В норме эти клетки обеспечивают иммунную защиту организма и представлены:
В-лимфоцитами, которые синтезируют антитела и обеспечивают гуморальный иммунитет;
Т-лимфоцитами, которые отвечают за клеточный иммунитет, непосредственно взаимодействуя с инородными телами (вирусами и бактериями).
Содержание:
Все клетки иммунной системы образуются в костном мозге. Часть незрелых клеток, предшественники лимфоцитов, поступает в тимус, где они созревают и преобразуются в Т-лимфоциты (тимусзависимые лимфоциты). Другая часть лимфоцитов заканчивает свое созревание в селезёнке и лимфатических узлах (В-лимфоциты, bursa-зависимые). На пути возможного попадания в организм чужеродных агентов находятся периферические лимфоидные органы, выполняющие барьерную функцию: миндалины и другие скопления лимфоидной ткани глоточного кольца, лимфоидные узелки в слизистой оболочке органов пищеварения, дыхания и мочевыводящих путей.
Неходжкинская лимфома может развиться из любого типа лимфоцитов на любом этапе их созревания, что и обуславливает разнообразие клеточного строения, особенности течения и клинической картины опухоли. В соответствии с морфологическим (клеточным) строением выделяют: В-клеточные и Т/NK- клеточные лимфомы со своими подвидами. Каждая лимфома имеет свой уникальный набор антигенов (иммунофенотип). Определение иммунофенотипа широко используется для диагностики конкретного типа НХЛ.
В зависимости от течения неходжкинские лимфомы делятся на:
- индолентные лимфомы. Характеризуются медленным, благоприятным течением, длительно не требующие специфического лечения.
- агрессивные лимфомы. Характеризуются быстрым прогрессированием опухоли, с выраженной клинической картиной, требуют немедленного лечения.
Причины и механизм развития неходжкинских лимфом
Причины развития большинства лимфом остаются неизвестными. Выделяют ряд этиологических факторов, общих для всех опухолей, которые могут способствовать возникновению НХЛ:
- Ионизирующая радиация.
- Химические вещества, обладающие канцерогенными свойствами.
- Неблагоприятные факторы внешней среды.
Доказана вирусная природа некоторых форм лимфом, в частности, лимфомы Беркитта (вирус Эпштейн-Барр), некоторых Т-клеточных лимфом (ретровирус HTLV-1).
Приблизительно 90 % случаев MALT-лимфом желудка (экстронодальная В-клеточная лимфома) связывают с инфицированием H. pylori.
Риск развития лимфом повышен при иммунодефицитных состояниях различной природы (ВИЧ-инфекция, аутоиммунные и наследственные заболевания и др.).
Иммунная клетка под воздействием причинных факторов останавливается на каком-либо этапе созревания, преобразуется в злокачественную и начинает бесконтрольно делиться, что ведет к возникновению опухоли. Неходжкинские лимфомы начинаются с одиночного опухолевого очага, который чаще всего локализуется в каком-либо лимфатическом узле (нодальное поражение), реже в других органах и тканях (экстранодальное поражение).
С течением времени происходит гематогенное (с кровотоком) или лимфогенное (с током лимфы) распространение опухоли с вовлечением в процесс костного мозга и центральной нервной системы.
Симптомы неходжкинских лимфом
Клинические проявления НХЛ будут зависеть от степени зрелости клеток, из которых построена опухоль, а также от места возникновения, опухолевой массы и стадии процесса.

Опухоли, построенные из зрелых клеток, имеют менее выраженную симптоматику, чем опухоли из незрелых форм клеток.
Проявления общих симптомов, связанных с биологической активностью опухоли, при НХЛ вариабельны. К ним относят:
- сильная потливость, так называемые проливные поты, в ночное время;
- резкое снижение веса в течение полугода;
- необъяснимые подъемы температуры тела;
- необъяснимый кожный зуд;
- слабость, быстрая утомляемость.
Почти половина лимфом возникает в лимфатических узлах. Пораженные лимфоузлы увеличиваются в размерах, при прощупывании плотные, безболезненные, не спаяны с окружающими тканями, часто сливаются в конгломераты.
Клиника лимфомы глоточного кольца характеризуется заложенностью носа, нарушением дыхания, ощущением инородного тела при глотании. Отмечается увеличение миндалин, возможно свисание бугристой, синюшного цвета опухоли из носоглотки. Возможно вовлечение в процесс слюнных желез, прорастание опухоли в полость носа, пазухи, основание черепа и орбиту со сдавлением зрительных и других черепно-мозговых нервов и развитием очаговой симптоматики. Часто обнаруживается увеличение шейных и подчелюстных лимфатических узлов.
Лимфомы, возникающие во внутригрудных лимфатических узлах и тимусе, вначале протекают бессимптомно. По мере прогрессирования процесса возникают симптом, обусловленные сдавлением и прорастанием органов и структур средостения:
- синдром верхней полой вены (одутловатость лица, синюшность кожных покровов лица и шеи, набухание вен лица и шеи);
- нарушение глотания;
- осиплость или потеря голоса;
- кардиальный синдром (боли в области сердца);
- респираторный синдром (одышка, сухой навязчивый кашель, боль в грудной клетке)
НХЛ, развивающиеся в брюшной полости (в аппендиксе, восходящей кишке, мезентериальных или других регионарных лимфатических узлах), также характеризуется бессимптомным началом болезни. Рост опухоли приводит к появлению от неинтенсивных болей в животе и диспептического синдрома (тошнота, вздутие, ощущение тяжести), до симптомов острого живота (сильные боли, напряжение брюшной стенки, рвота) и кишечной непроходимости (задержка стула и отхождения газов, рвота).
Лимфома с поражением кожи проявляется в виде папул, узелков, бляшек с шелушением, может наблюдаться зуд и изъязвления. Элементы сыпи могут быть различного цвета — от ярко-розовых до багровых. Характерно увеличение лимфатических узлов.
Поражение ЦНС может встречаться при любом типе лимфомы. Характерными будут такие симптомы как головная боль, нарушения слуха и зрения, парезы и параличи.
Вовлечение в процесс костного мозга будет сопровождаться нарушением нормального кроветворения, и проявляться панцитопенией (снижением количества всех клеток крови).
При органном поражении НХЛ симптоматика будет складываться из признаков, характерных злокачественному новообразованию соответствующего органа.
Стадии неходжкинских лимфом
Клиническая стадия лимфом определяется на основании проведенного комплекса диагностических исследований перед назначением лечения.
| Стадия I | Поражение одной лимфатической зоны или лимфатической структуры (I). |
| Поражение одной лимфатической зоны или лимфатической структуры с вовлечением прилежащих тканей (IE). | |
| Локализованное поражение одного экстралимфатического органа (IE). | |
| Стадия II | Поражение двух и более лимфатических зон по одну сторону диафрагмы (II). |
| Поражение двух и более лимфатических зон по одну сторону диафрагмы с вовлечением прилежащих тканей (IIE). | |
| Локализованное поражение одного экстралимфатического органа и его регионарных лимфатических узлов с или без поражения других лимфатических зон по ту же сторону диафрагмы (IIE). | |
| Стадия III | Поражение лимфатических узлов по обе стороны диафрагмы (III), которое может сочетаться с локализованным поражением одного экстралимфатического органа или ткани (IIIE), или с поражением селезенки (IIIS), или с поражением того и другого (IIIE + S). |
| Стадия IV | Диссеминированное (многофокусное) поражение одного или нескольких экстралимфатических органов с или без поражения лимфатических узлов. Изолированное поражение экстралимфатического органа с поражением отдаленных (не региональных) лимфатических узлов. |
Каждая стадия подразделяется на подстадии в зависимости от наличия общих симптомов:
Подстадия А характеризуется отсутствием общих симптомов, подстадия В их наличием.
Также для 1-3 стадии могут быть характерны:
- Е – локализованное экстранодальное поражение.
- S – поражение селезенки.
Диагностика неходжкинских лимфом
Диагностика НХЛ включает в себя проведение ряда лабораторных и инструментальных методов исследования. Однако первичным является осмотр пациента со сбором жалоб, оценкой его общего состояния, уточнением наследственного анамнезаи наличия у него хронических или других опухолевых заболеваний. Проводится прощупывание всех групп периферических лимфатических узлов и оценка их размеров, эластичности, подвижности, наличия болезненности, а также пальпаторное исследование печени и селезенки. Оценивается состояние небных миндалин и носоглотки.
Назначается ряд лабораторных методов исследования:
- общий анализ крови с подсчетом лейкоцитарной формулы и определением количества тромбоцитов;
- биохимический анализ крови с оценкой функции печени (билирубин, общий белок, альбумин) и почек (мочевина, креатинин), определением уровня электролитов (K, Na, Ca), уровня лактатдегидрогеназы, мочевой кислоты;
- коагулограмма;
- измерение диуреза и общий анализ мочи;
- определение маркеров вирусных инфекций: вирус Эпштейна — Барра, ВИЧ, гепатиты;
- определение сывороточных иммуноглобулинов.
Выполняются инструментальные методы диагностики:
- УЗИ лимфатических узлов, органов брюшной полости и малого таза.
- Рентгенография органов грудной клетки. Позволяет установить увеличение тимуса, лимфатических узлов средостения, выявить очаги в легких.
- КТ для оценки состояния органов грудной, брюшной полости и органов малого таза, шеи.
- МРТ при симптомах поражения ЦНС и спинного мозга.
- Остеостинциграфия и рентгенография костей при наличии костных болей.
- Эндоскопическое исследование желудка с биопсией и определением инфицирования Helicobacter рylori.
Во всех случаях для верификации диагноза обязательным является проведение биопсии опухолевых тканей для гистологического исследования и определения иммунофенотипа опухоли.
Для определения вовлечения в опухолевый процесс костного мозга проводится биопсия костного мозга и миелограмма.
Лечение неходжкинских лимфом
Определение тактики лечения основывается на уточнении специфического типа лимфомы, стадии опухоли и ее локализации.
Основным методом лечения НХЛ является химиотерапия, применяемая в виде комбинации различных цитостатических препаратов. Лечение проводится короткими курсами с интервалом 2 — 3 недели. Для определения чувствительности опухоли к определенному курсу химиотерапии проводится не менее двух циклов лечения. При отсутствии лечебного эффекта обоснован переход на другой режим лечения. При лимфомах, не отвечающих на стандартную тактику лечения, возможно проведение высокодозной химиотерапии с последующей трансплантацией костного мозга.
В комбинации с химиотерапией возможно проведение лучевой терапии.
Оперативное лечение применятся редко и показано только при одиночных опухолях желудочно-кишечного тракта.
Возможно применение препаратов направленного действия — антител против антигенов опухолевых клеток — таргерная терапия. Доказана их высокая эффективность в клинических испытаниях и практическом применении.
Неходжкинские Лимфомы
Вам поставили диагноз: Неходжкинская лимфома?
Наверняка Вы задаётесь вопросом: что же теперь делать?
Подобный диагноз всегда делит жизнь на «до» и «после». Все эмоциональные ресурсы пациента и его родных брошены на переживания и страх. Но именно в этот момент необходимо изменить вектор «за что» на вектор «что можно сделать». Очень часто пациенты чувствуют себя безгранично одинокими вначале пути. Но вы должны понимать - вы не одни.
Предлагаем вашему вниманию краткий, но очень подробный обзор Неходжкинской Лимфомы.
Его подготовили высоко квалифицированные специалисты Отдела лекарственного лечения злокачественных новообразований МРНЦ имени А.Ф. Цыба и Отдела лекарственного лечения опухолей МНИОИ имени П.А. Герцена – филиалов ФГБУ «НМИЦ радиологии» Минздрава России под редакцией заведующих отделами, д.м.н. ФАЛАЛЕЕВОЙ Н.А. и д.м.н. ФЕДЕНКО А.А.
Филиалы и отделения, где лечат неходжкинские лимфома
МНИОИ им. П.А. Герцена – филиал ФГБУ «НМИЦ радиологии» Минздрава России.
Отдел лекарственного лечения опухолей
Заведующий отделом, д.м.н. ФЕДЕНКО Александр Александрович
тел: 8 (494) 150 11 22
МРНЦ им. А.Ф. Цыба – филиал ФГБУ «НМИЦ радиологии» Минздрава России.
Отдел лекарственного лечения злокачественных новообразований
Заведующая отделом, д.м.н. ФАЛАЛЕЕВА Наталья Александровна
тел: 8 (484) 399 – 31-30
Неходжкинские лимфомы
– Это историческое название, обозначающее, что данный тип лимфомы не является лимфомой Ходжкина. Неходжкинские лимфомы (НХЛ) – это большая группа опухолей лимфоидной системы, внутри которой выделяют наиболее часто встречающиеся В-клеточные лимфомы, возникшие из В-лимфоцитов и Т-клеточные лимфомы- из Т-лимфоцитов. НХЛ подразделяют на агрессивные и вялотекущие основываясь на характере течения опухоли, подходы к лечению вялотекущих и агрессивных лимфом разняться. Вялотекущие (индолентные) лимфомы на сегодняшний день неизлечимы. Благодаря их медленному развитию, иногда от момента установки диагноза до начала лечения проходит длительное время, исчисляемое годами. Агрессивные лимфомы следует лечить сразу после обнаружения, целью лечения в этих случаях является достижение ремиссии. Опухолевые клетки при агрессивных лимфомах делятся очень быстро, опухоль может стремительно увеличивать свои размеры, симптомы болезни возникают быстро.
К факторам, предрасполагающим развитию неходжкинских лимфом относиться:
· Вирус Эпштейн-Барр, Т-лимфотропный вирус человека, вирус герпеса 8 типа.
· Вирус гепатита С.
· Хроническая бактериальная инфекция: Helicobacter pylori, Borelliaburgdorferi.
· Прием лекарственных препаратов, подавляющих иммунитет.
Клиническая картина
Как правило, манифестация НХЛ сопровождается симптомами, которые носят общий характер, например- повышение температуры тела, общая слабость, повышенная утомляемость, потеря веса, суставные боли и т.д. Можно сказать, что злокачественное заболевание крови на начальных этапах может прятаться под «масками» других заболеваний. Не напрасно же среди гематологов существует профессиональная поговорка: «Лимфома – обезьяна любой болезни». В связи с наличием общих жалоб часто ошибочно устанавливаются неверные диагнозы, назначается симптоматическое лечение. В результате в гематологическую клинику пациент поступает лишь спустя время и уже в тяжелом состоянии, а диагноз устанавливается на поздней стадии, что ухудшает прогноз и течение заболевания, создает дополнительные терапевтические проблемы.
В типичном случае поражаются лимфатические узлы, их локализация крайне вариабельна и в незначительной степени зависит от варианта НХЛ. Симптомы болезни будут зависеть от расположения растущих лимфатических узлов. Довольно часто в опухолевый процесс вовлекаются селезенка и костный мозг. Поражение селезёнки проявляется тяжестью и дискомфортом в левой половине живота, вовлечение в процесс костного мозга можно заподозрить на основании анализа крови. Возможно поражение органов, не относящихся к лимфатической системе, например, желудок, легкие, головной мозг, молочная железа, яички, кости, кожа и т.д. при этом симптомы болезни будут соответствовать поражению органа. В этом случае речь идет о экстранодальном (=вне лимфатической системы) варианте НХЛ.
Диагноз
В настоящее время отличить один вариант лимфомы от другого возможно лишь при проведении комплексного иммуноморфологического исследования, подкрепленного в ряде случаев цитогенетическим и молекулярными анализами опухолевой ткани, взятой при биопсии. Выбор программы лечения, в том числе с применением новейших таргетных препаратов, также основывается на детальном изучении иммунологического и генетического портрета опухоли.
Обследование. См. раздел Лимфома Ходжкина.
Лечение неходжкинских лимфом
План лечения определяется в каждом случае индивидуально и зависит от иммуноморфологического варианта НХЛ, ее молекулярно-генетических особенностей, стадии заболевания, наличия факторов прогноза и общих симптомов.
Хирургический метод
В лечении лимфом практически не используется. С целью диагностики заболевания выполняется биопсия пораженного лимфатического узла или ткани.
«Наблюдай и жди»
При некоторых вариантах индолентных НХЛ, когда клинические проявления болезни минимальны, а состояние больного хорошее, лечение не начинается сразу после установления диагноза, пациент остается под наблюдением врача до наступления «симптомной» болезни. Такой подход возможен при фолликулярной лимфоме, лимфоме из клеток маргинальной зоны, при хроническом лимфолейкозе. Выжидательная тактика неприменима к агрессивным вариантам лимфом, когда лечение необходимо начинать сразу после установления диагноза.
Лекарственная терапия неходжкинских лимфом
Клетки лимфомы обычно обладают высокой чувствительностью к химиопрепаратам, причем тем более агрессивно ведет себя опухоль, тем, как правило, большей чувствительностью она обладает. Прогноз при НХЛ кардинально изменился за последние два десятилетия. Причиной тому стало развитие нового направления лекарственной терапии рака- таргетной, т.е. лечение с использованием препаратов направленного действия. Так, эффективность анти- CD20-антитела ритуксимаба при многих видах В-клеточных лимфом оказалась настолько высока, что время после начала применения препарата получило название «эра ритуксимаба».
Изучение иммунологических, биологических и функциональных свойств отдельных видов НХЛ привело к пониманию механизмов их возникновения и развития. Эти знания легли в основу создания самых современных программ лекарственного лечения каждого иммуноморфологического варианта лимфомы. Терапевтические программы сегодня – это, как правило, сочетание определенных режимов цитостатиков с новейшими таргетными препаратами. Использование указанных режимов позволяет достигать длительные и стойкие ремиссии даже при генерализованных стадиях лимфом.
Лучевая терапия неходжкинских лимфом
При лучевой терапии воздействие осуществляется непосредственно на пораженные лимфатические узлы и ткани организма, содержащие опухолевые клетки, которые чрезвычайно чувствительны к воздействию радиации. Индивидуальная программа лечения пациента обычно включает лекарственное лечение, которое проводится первым этапом и лучевую терапию обычно в качестве закрепляющего второго этапа.
В ряде случаев, после завершения двух этапов лечения пациенту назначается поддерживающеелечение, включающее в себя, как правило, таргетные иммунопрепараты.
Филиалы и отделения Центра, в которых лечат неходжкинскую лимфому
ФГБУ «НМИЦ радиологии» Минздрава России обладает всеми необходимыми технологиями лучевого, химиотерапевтического и хирургического лечения, включая расширенные и комбинированные операции. Все это позволяет выполнить необходимые этапы лечения в рамках одного Центра, что исключительно удобно для пациентов.
Отдел лекарственного лечения злокачественных новообразований МРНЦ имени А.Ф. Цыба – филиал ФГБУ «НМИЦ радиологии» Минздрава России
Заведующая отделом, д.м.н. ФАЛАЛЕЕВА Наталья Александровна
8 (484) 399 – 31-30, г. Обнинск, Калужской области
Отдел лекарственного лечения опухолей МНИОИ имени П.А. Герцена –филиал ФГБУ «НМИЦ радиологии» Минздрава России
Заведующий отделом, д.м.н. ФЕДЕНКО Александр Александрович
Неходжкинские лимфомы
Неходжкинские лимфомы лечение, симптомы, признаки, прогноз.
Содержание:
Лимфомы – это вид злокачественных опухолей, которые поражают лимфатическую систему. Неходжкинские лимфомы включают в себя все лимфомы, кроме лимфомы Ходжкина. Эта группа заболеваний очень неоднородна и включает в себя очень разные по характеру течения, по своему строению и характеристикам.

В структуре онкологической заболеваемости доля неходжкинских лимфом (лимфосарком) составляет примерно 3 %. В Беларуси этот показатель несколько ниже.
Стоит отметить, что за последние 10 лет наблюдается увеличение заболеваемости НХЛ во многих странах мира, в том числе и в Беларуси. Если в 2001 год наблюдалось 470 случаев, то в 2010 году уже 638, т.е. заболеваемость выросла в 1,4 раза.
Как возникает неходжкинская лимфома?
В настоящее время считается, что лимфома возникает, когда здоровые лимфатические клетки по разным причинам останавливают свое развитие на различных этапах. Из них формируются опухолевые клетки различных типов лимфом.
Лимфомы, возникающие из Т- и В-линий лимфоцитов, а также из клеток различной степени дифференцировки, имеют уникальный набор антигенов (иммунофенотип). Определение иммунофенотипа наряду с определением морфологических характеристик широко используется в диагностике. Эта процедура осуществляется при помощи панели диагностических моноклональных антител.
Причины возникновения неходжкинских лимфом
На данный момент причины возникновения большинства видов неходжкинских лимфом остаются неясными, но для некоторых форм лимфом установлена связь с различными факторами.
1. Снижение иммунитета (иммунодефицит)
Значительно повышен риск развития заболевания при иммунодефицитных состояниях различной природы (включая ВИЧ-инфекцию, ряд аутоиммунных заболеваний и наследственных синдромов с иммунодефицитной составляющей и др.).
2. Вирусные заболевания
В ряде случаев доказана роль вирусов в развитии лимфосарком – вируса Эпштейн-Барр для эпидемической лимфомы Беркитта, а также вируса Т-клеточной лейкемии/лимфомы в развитии ряда Т-клеточных лимфом с эндемическим характером распространения.
3. Некоторые бактериальные инфекции
Важным фактором риска развития MALT-лимфомы желудка в настоящее время считают кампиллобактериоз. Подтверждением этому служит то, что антибактериальное лечение, направленное против Helicobacter pylori, во многих случаях (до 70 %) вызывает регрессию лимфомы желудка.
4. Внешнее воздействие
Ряд физических и химических факторов также может способствовать развитию неходжкинских лимфом.
- факторы окружающей среды (ионизирующая радиация, диоксин);
- лекарственные препараты (цитостатическая терапия);
- лучевая терапия.
Диагностика и симптомы неходжкинской лимфомы
Во время диагностики, прежде всего, исследуется уникальный иммунофенотип злокачественных клеток. Это исследование проводится с помощью имуннологических методов и позволяет установить линейную принадлежность клеток (Т- или В-), а также степень их дифференцировки (предшественники или зрелые клетки).
К сожалению, выявить лимфосаркому на ранней стадии удается редко.
Чаще всего первым симптомом является увеличение лимфатических узлов, но т.к. это заболевание может протекать по-разному и с различными симптомами, оно может выявляться врачами самых разных специальностей.
При индолентных лимфосаркомах отмечается медленное увеличение нескольких групп лимфатических узлов.
Более агрессивные лимфомы (лимфота Беркитта, лимфобластная лимфома) прогрессируют очень быстро и общие симптомы появляются раньше.
Также симптомы зависят от локализации опухоли. Например, первым проявлением лимфомы тонкой кишки может стать кишечная непроходимость или перфорация стенки кишки.
Лимфома может быть диагностирована при:
- биопсии миндалины;
- при гастроскопии;
- исследовании ЦНС;
- дерматологом при биопсии кожи;
- при выполнении общего анализа крови.
Потеря массы тела, лихорадка неясного происхождения, необъяснимое ухудшение общего состояния также могут быть первыми симптомами неходжкинской лимфомы.
Течение заболевания
Прогрессирование лимфомы в значительной мере определяется морфологией и иммунологией клетки, положившей начало опухолевому росту.
Так, если клетка трансформировалась в злокачественную на раннем этапе своего развития и не успела покинуть костный мозг, то в результате имеется картина преимущественно костно-мозговых опухолей (острый лимфобластный лейкоз, лимфобластная лимфома).
В тех случаях, когда родоначальницей опухолевого клона становится более зрелая клетка лимфоидного ряда, в процессе созревания покинувшая костный мозг, поражение исходно локализуется в периферических лимфоидных органах и характеризуется более благоприятным течением.
Виды неходжкинских лимфом



Индолентные лимфомы отличаются, как правило, медленным ростом, длительным течением (годами), а также тем, что излечение больных практически невозможно даже в случаях достижения полной регрессии опухоли.
Агрессивные лимфомы (промежуточной и высокой степени злокачественности) характеризуются быстрым ростом, низкой выживаемостью в отсутствие лечения (месяцы и даже недели), высокой чувствительностью к химиолучевым воздействиям и возможностью излечения у значительного числа больных.
Неходжкинская лимфома лечение

Тактика лечения больных НХЛ зависит от вида опухоли, ее локализации.
Основным методом лечения неходжкинских лимфом является химиотерапия и лучевая терапия.
Лечение проводится короткими курсами с интервалом 2-3 недели.
В ходе лечения наблюдают реакцию опухоли на препараты, оценивают ее регрессию и при необходимости корректируют режим лечения.
Хирургическое лечение применяют очень ограниченно и только при определенных типах лимфом (например, при лимфомах желудочно-кишечного тракта), но даже в этих ситуациях его дополняют другими методами.
Развитие молекулярной биологии, революционно расширившее наши представления о развитии лимфом и наши диагностические возможности, в значительно меньшей мере повлияли на терапевтические подходы.
В настоящее широко применяяется лишь один ритуксимаб (антиCD20) в лечении В-клеточных лимфом.
Длительное течение индолентных лимфом и отсутствие симптомов (исключая лимфаденопатию) у большинства больных на момент постановки диагноза делают возможной выжидательную тактику.
Лечение начинают при появлении клинической симптоматики (симптомов интоксикации или симптомов, связанных с локальным ростом/инвазией опухолевых узлов).
Лечение химиотерапией требует обязательной реабилитации, соблюдения диеты и режима отдыха.
В случаях, когда имела место быть высокодозная химиотерапия проводят трансплантацию стволовых гемопоэтических клеток.
Неходжкинская лимфома

Неходжкинскими лимфомами (лимфосаркомой, НХЛ) называют злокачественные поражения лимфатической системы, которые не являются лимфомой Ходжкина. Это группа онкологических заболеваний, отличающихся между собой по степени злокачественности, скорости развития опухолевого процесса и имеющейся симптоматике. В основе патологии лежит злокачественная пролиферация В-лимфоцитов (реже Т-лимфоцитов). Опухоли могут формироваться в лимфоузлах, костном мозге, тканях селезенки и других органах.
Неходжкинская лимфома встречается чаще лимфогранулематоза (лимфомы Ходжкина). Болезнь выявляют во всех возрастных группах, однако чаще у людей старшего возраста. На 100 тыс. населения регистрируется 1-7 случаев патологии. По статистическим данным, около 4% новых онкологических диагнозов приходятся на НХЛ.
Заболевание развивается в условиях воздействия на организм онкогенных факторов или в случае подавления естественных механизмов антионкогенной защиты. Данные процессы ведут к нарушениям клеточного цикла лимфоцитов, в результате чего изменяется их морфология, свойства и функции. Атипичные клетки оседают в лимфатической системе, бесконтрольно делятся, формируя опухоли. Злокачественные клетки разносятся по организму вместе с лимфой и кровью, что сопровождается образованием метастазов.
Лимфомы, произрастающие в лимфатической ткани, называют нодальными. При локализации опухоли в других органах — экстранодальными. Ориентируясь на структуру, выделяют фолликулярные и диффузные лимфомы. В зависимости от скорости прогрессирования, опухоли могут быть индолентными (вялое развитие), агрессивными и высокоагрессивными.
Симптомы неходжкинской лимфомы
Неходжкинская лимфома может проявляться по-разному. Клиническая картина зависит от места расположения, гистологического типа и поведения первичной опухоли. Чаще всего заболевание сопровождается следующими симптомами:
- Увеличение лимфатических узлов. На начальных этапах лимфоузлы увеличиваются незначительно, остаются подвижными и не доставляют особого дискомфорта. На поздних стадиях отмечается их групповое поражение с образованием крупных конгломератов.
- Симптомы компрессии тканей. Увеличенные лимфоузлы могут сдавливать окружающие ткани с развитием дисфункции определенного органа. Это могут быть нарушения носового дыхания, глотания, отек лица, одышка, желтуха, боли в грудной клетке и брюшной полости и пр.
- Неспецифические проявления. Неходжкинская лимфома может провоцировать общие симптомы, которые невозможно отнести к заболеванию конкретного органа. Онкологическому процессу сопутствует беспричинная лихорадка, потливость, астения, сонливость, потеря веса и пр.
При экстранодальном расположении опухоли клинические проявления соответствуют дисфункции вовлеченного в патологический процесс органа. Например, лимфома желудка может провоцировать нарушения пищеварения, боли в эпигастральной области и внутренние кровотечения. Абдоминальные опухоли вызывают кишечную непроходимость, асцит, мальабсорбцию и перитонит. Поражение кожи проявляется узловатой эритемой в виде бугорков на коже, папул или бляшек.
Причины неходжкинской лимфомы
- наличие кровных родственников с лимфомами;
- врожденные и приобретенные иммунодефициты;
- терапия иммуносупрессорами;
- контакты с канцерогенными химическими веществами;
- аутоиммунные заболевания (ревматоидный артрит, аутоиммунный тиреоидит и пр.);
- хроническое воспаление в организме.
Получить консультацию
Если у Вас наблюдаются подобные симптомы, советуем записаться на прием к врачу. Своевременная консультация предупредит негативные последствия для вашего здоровья.
Узнать подробности о заболевании, цены на лечение и записаться на консультацию к специалисту Вы можете по телефону:

Почему «СМ-Клиника»?
Диагностика неходжкинской лимфомы
Подозрения в отношении заболевания возникают при безболезненном увеличении нескольких групп лимфатических узлов и наличии общих неспецифических симптомов дисфункции со стороны других органов. Основным методом диагностики является биопсия с последующим цитологическим, цитогенетическим и иммуногистохимическим анализом. Правильная верификация опухоли играет решающую роль при подборе терапевтической тактики. При точной постановке диагноза повышаются шансы достижения ремиссии.
Увеличение периферических и внутренних лимфоузлов определяют с помощью визуализационных диагностических процедур. В рамках первичной диагностики применяют ультразвуковое сканирование. С целью выявления метастазов и стадирования заболевания проводят МРТ внутренних органов и сцинтиграфию костей. В ряде случаев применяют эндоскопические методы.
Лабораторная диагностика включает общеклинические анализы, скрининг на инфекции с целью выявления факторов риска и биохимическое исследование крови для оценки функции внутренних органов.
Мнение эксперта
Успешность лечения онкологических заболеваний зависит от множества факторов. Это форма и стадия онкопроцесса, гистологический тип опухоли, состояние организма пациента и наличие сопутствующих патологий.
Важную роль играют и технологические возможности медицинского центра, а также квалификация онкологов. Персонифицированный подход и лечение неходжкинских лимфом в соответствии с последними научными разработками и международными протоколами способствуют достижению лучших прогнозов для пациента.
Врач-онколог, врач-гематолог, врач-радиолог (лучевой терапевт) высшей категории, д.м.н., профессор, отличник здравоохранения РФ, ведущий специалист
Лечение неходжкинской лимфомы
Лечение неходжкинской лимфомы проводится в онкогематологическом отделении. Терапевтическую тактику подбирают в индивидуальном порядке, ориентируясь на иммуноморфологический и генетический портрет опухоли. Если заболевание прогрессирует медленно и бессимптомно, может применяться выжидательная тактика.
Основными методами лечения НХЛ являются следующие:
- Химиотерапия. Подразумевает применение препаратов, которые подавляют активность опухоли.
- Лучевая терапия. Ионизирующее облучение применяется в целях разрушения опухоли при ограниченных формах заболевания.
- Иммунотерапия. Применяются препараты моноклональных антител, которые активизируют иммунитет организма против злокачественных клеток.
- Таргетная терапия. Подразумевает лечение препаратами, которые избирательно уничтожают клетки опухоли, не повреждая здоровые органы и ткани.
- Хирургия. Предполагает удаление лимфатических узлов при ограниченном поражении лимфатической системы. В некоторых случаях проводят трансплантацию костного мозга с целью восстановления нормального синтеза иммунных клеток.
НХЛ считается потенциально излечимой онкопатологией, однако прогнозы зависят от варианта течения болезни и вида опухоли. В настоящее время способы лечения неходжкинской лимфомы совершенствуются. Ранняя диагностика заболевания и комбинация различных методов терапии позволяют существенно продлить и улучшить качество жизни больного.
Специалисты медицинского центра «СМ-Клиника» успешно проводят диагностику и лечение неходжкинской лимфомы. С целью верификации диагноза применяются наиболее современные методы диагностики. Все исследования можно пройти в комфортных условиях и за короткие сроки в условиях нашего Центра. Лечение подбирается в соответствии с последними международными рекомендациями. В клинике используются наиболее современные методы с доказанной эффективностью.
Неходжкинская лимфома
Многие виды рака могут курсировать и метастазировать по лимфатической системе, но только лимфомы зарождаются там. Таким образом, лимфома считается онкологическим заболеванием иммунной системы человека.Она приводят к увеличению лимфоузлов и поражают разные внутренние органы. Также для лимфомы характерно образование плотной опухоли.
В современной классификации выделяют 2 подтипа: Лимфома Ходжкина — это рак лимфатической системы. Все остальные злокачественные лимфомы называют Неходжкинские.
Неходжкинская лимфома (НХЛ) — это группа онкологических заболеваний лимфатической системы, которая имеет злокачественный характер. Чаще всего идет поражение одного из лимфоузлов и далее распространяется по всему телу. Код МКБ С85.
Термин “неходжкинская”, означает только то, что это точно не болезнь Ходжкина, это вся остальная, большая группа лимфом. Главным отличием этих заболеваний является наличие в крови аномальной клетки Рида-Штернберга, которая присутствует только при лимфоме Ходжкина. Основной причиной разделения является разные методы лечения и исход.
Причины и факторы риска развития
У неходжкинских лимфом, нет одной общей причины, так как это целая группа заболеваний, то и причин может быть много.
Изменение на генетическом уровне.
В связи с биотехническим прогрессом и развитием генетики, сегодня ученые достигли больших успехов в определении предрасположенности к развитию НХЛ. В организме человека существуют гены, которые стимулируют клетки постоянно расти и делиться, а в то же время, другие гены контролируют деление этих клеток. Бывают случаи, когда происходят мутация в этих генах, что и нарушает их работу.
Иногда эта мутация передается от родителей по наследству. Но все же чаще всего изменения связанные с НХЛ, приобретаются в течении жизни под действием различных факторов:
— Контакт с радиационным или магнитным излучением;
— Химические вещества, что попадают в организм в больших количествах.
И сегодня ученые уже достаточно много изучили о мутациях в генах, связанных с НХЛ, что позволяет определять точный вид лимфомы и соответственно лечение. Но все же еще очень много работы и исследований ждет впереди.
Поражение иммунной системы
Лимфома, это заболевание иммунной системы, поэтому любые изменения и сбои в ее работе могут привести к ее развитию.
Сюда относят людей с постоянными хроническими инфекциями, или некоторыми вирусами: Вирус Эпштейн-Барра, Вирус Т-клеточного лейкоза, гепатиты.
Следующей категорией причин, являются иммунодефицитные заболевания. Еще в 1987 году Центр по контролю и профилактике заболеваний (CDC) внес СПИД, как предиктор образования онкологических заболеваний, в том числе и большой риск появления НХЛ.
И конечно же аутоиммунные заболевания, когда иммунная система атакует собственный организм, это не может хорошо сказаться на общей ее работе. Такие заболевания как синдром Шегрена, ревматоидные артриты и волчанка, могут привести к развитию лимфом.
Факторы риска, что провоцируют развитие НХЛ
К таким факторам относят общепринятые онкопровоцирующие факторы:
- Люди, которым проводили трансплантацию органов или стволовых клеток;
- Постоянный контакт с облучением, химикатами или другими канцерогенами;
- Возраст старше 60-ти лет;
- Сильная лучевая- или химиотерапия.
Какие бывают неходжкинские лимфомы?
Сегодня ученые выделяют два типа неходжкинских лимфом, которые связаны с их происхождением:
- В-лимфоцитарные НХЛ. Предшественники В-клетки, зрелая клетка и разрастание В-клеток с неопределенным злокачественным потенциалом;
- Т-лимфоцитарные и естественные клетки-киллеры (NK-лимфоциты) НХЛ. Предшественники Т-клеток, экстранодальные зрелые Т-клетки и NK-клетки, а также нодальные Т- и NK-клетки.
В 2016 году, ВОЗ пересмотрела полную классификацию НХЛ, и теперь туда включены более 60 подтипов. Она считается наиболее точной и информативной, так как там учтено все: генотипы, иммунофенотипы и много других характеристик опухоли.
Отдельно стоит выделить клиническую классификацию за течением опухоли.
— Индолентная. Медленное распространения, поражается костный мозг, печень и селезёнка. Чаще всего пациенты живут долго, иногда даже без лечения.
— Агрессивная. Резкое проявление, с быстрым ухудшением общего состояния организма, часто наблюдаются метастазы. Без лечения, пациент может прожить до нескольких лет, но они легко поддаются общепринятым принципам лечения.
— Высокоагрессивные. Тяжело лечатся, клиника появляется сразу, тяжело поддается лечению. Без лечения смерть наступает уже через несколько месяцев.
Дополнительно, НХЛ условно разделяют за локализацией опухоли:
— НХЛ желудка или кишечника;
— НХЛ головного мозга;
— НХЛ грудной клетки.
Классификация стадирования Лугано, используется для того, чтобы врач мог понять степень распространения рака.
Первая стадия
Наличие одного пораженного лимфоузла или одного внутреннего органа.
Вторая стадия
Лимфома обнаружена в двух и более группах лимфоузлов, но все они с одной стороны диафрагмы(снизу или сверху). Или группы лимфоузлов находится в одной локализации соседнего органа.
Третья стадия
НХЛ находящиеся сверху и снизу диафрагмы и в селезенке.
Четвертая стадия
Лимфомы в лимфатических узлах и в костном мозге\печени\легких.
Клиническое проявления и симптоматика
Симптоматика неходжкинской лимфомы делить на два условных типа: общая и привязанная к локализации развития опухоли.
К общей симптоматике относят:
- Беспричинное повышение температуры тела;
- Слабость и усталость даже после незначительной нагрузки;
- Увеличение лимфоузлов;
- Ночная потливость;
- Слишком частые инфекционные заболевания;
- Резкая потеря веса;
В зависимости от локализации НХЛ может давать такие дополнительные симптомы:
* Лимфомы желудка и органов брюшной полости. Могут вызывать боль в животе, вздутие, селезенки, тошноту, рвоту и расстройства стула. При поражении печени и желчных проток, может развиваться желтуха.
* НХЛ грудной клетки. Чаще всего, опухоль расположена в тимусе, что за грудиной. Таким образом она начинает давить на смежные органы, что вызывает боль за грудиной, кашель, ощущения удушья.
* НХЛ мозга. Вызывают головную боль, усталость, расстройствами речи или двоение в глазах.
* Кожные лимфомы. В первую очередь появляется зуд, выпуклость на коже и покраснение.
Так как неходжкинская лимфома снижает иммунный ответ нашей защитной системы, то к ней могут прибавиться инфекционные заболевание, что будут добавлять свою собственную симптоматику.
В зависимости от скорости развития опухоли симптоматика может развиваться довольно быстро при агрессивной НХЛ или быть долгое время полностью бессимптомной на протяжении нескольких лет.
Диагностические мероприятия
Диагностика неходжкинских лимфом начинается с первого врачебного осмотра и сбора анамнеза. В зависимости от жалоб, врач строит всю стратегию исследования пациента. Например, неходжкинская лимфома индолентного течения часто диагностируется на профилактических осмотрах, так как четкой симптоматики не дает.
Во время осмотра, врач в первую очередь обращает внимание на все группы лимфатических узлов. Он пальпирует и оценивает их размер, консистенцию, чувствительность и форму.

Для того чтобы увидеть глубокие лимфатические узлы, можно использовать: рентгенографию, компьютерную томографию, МРТ.
Если хоть один из узлов вызывает подозрение, он направляет пациента на пункцию содержимого узла.
В случае выявление опухоли, необходимо провести прицельную биопсию ткани. Дальше ее будет оценивать лаборант, который точно определит НХЛ и ее подтип.
Дополнительно может назначаться биопсия и лабораторное исследования костного мозга, так как именно там начинают образовываться иммунные клетки.
Конечно, все эти процедуры сопровождаются клиническим анализом крови, где лаборант может четко посчитать количество патологических клеток.
При наличии инфекции проводятся скрининговые тесты для того, чтобы определить возбудителя.
На каждом пораженном лимфоците, существуют некий антиген, который можно вычислить и определить конкретный вид НХЛ. Чтобы их выявить используют иммуногистохимический анализ, который позволяет провести дифференциацию между разными онкологическим заболеваниями.
Прогностические критерии
Прогноз неходжкинских лимфом строго зависит от некоторых критерий
- Возраст;
- Стадия;
- Лимфома в или вне лимфатической системы;
- Активность больного согласно рекомендациям Восточной Кооперации Онкологов (ECOG)
- Повышение лактатдегидрогеназы(ЛДГ).
В зависимости от этих критерий, рассчитывается международный прогностический индекс (IPI) для неходжкинских лимфом.
В первую очередь необходимо оценить активность пациента, согласно рекомендаций ECOG.
0 — нормальная физическая активность, без ограничений;
1 — незначительное ограничение из-за появления симптомов заболевания, но без проблем выполняет не физическую работу;
2 — пациент полностью сам себя обслуживает, но не может выполнять задачи, требует много отдыха, не больше половина солнечного дня проводить лежа;
3 — пациент проводит в постели больше половины дня, требует помощи при элементарных действиях(поесть, в туалет сходить);
4- пациент находится в постели целый день, необходимый круглосуточный присмотр и уход;
Читайте также:
